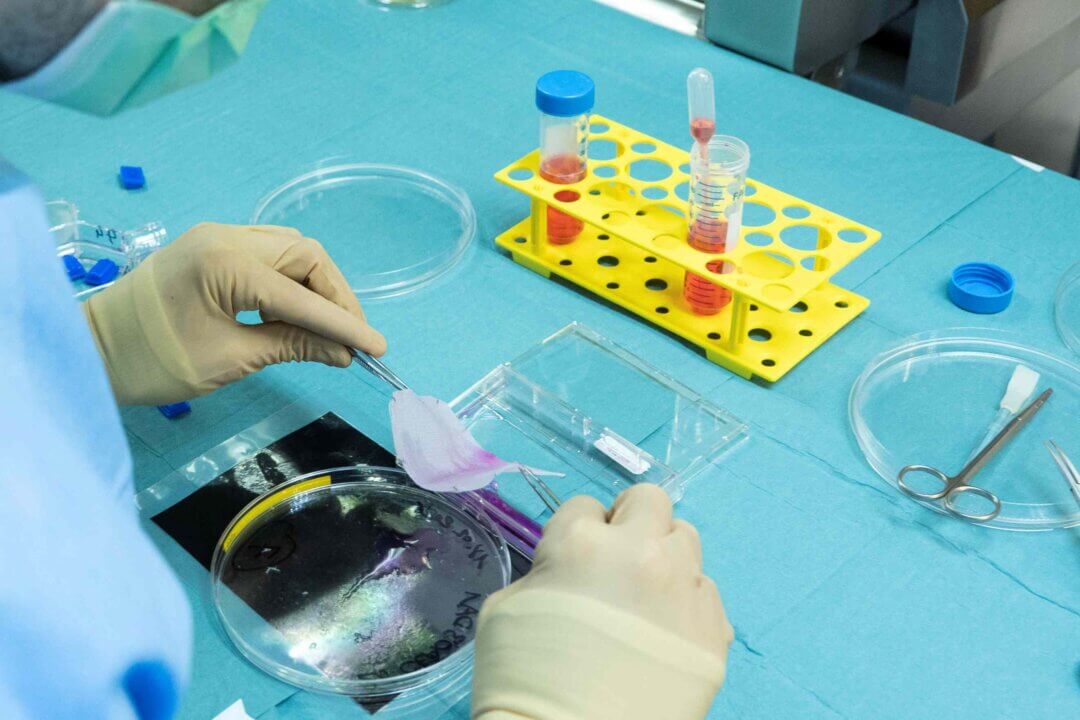

Contexte
Le drame survenu à Crans-Montana le 1er janvier 2026 a causé des brûlures graves sur de nombreuses victimes, essentiellement des mineurs et jeunes adultes, nécessitant des soins longs et hautement spécialisés.
Objectifs
Soutenir le Centre romand des brûlés, le Centre de production cellulaire du CHUV ainsi que les équipes multidisciplinaires mobilisées dans la prise en charge des victimes de la tragédie.
actions
- Renforcer la capacité du Centre de production cellulaire du CHUV appelé à fournir des souches de peau ;
- Proposer des formations ciblées aux professionnels mobilisés auprès des jeunes patients victimes de l’incendie ;
- Soutenir les équipes multidisciplinaires dans leur engagement auprès de ces patients ;
- Soutenir le processus de réhabilitation des patients sur le long terme.
Partenaires
 Découvrir
Découvrir

La Fondation CHUV soutient les missions de recherche, formation et soins du CHUV, en plaçant les patients, leurs proches et le personnel médical et soignant au cœur de ses actions.